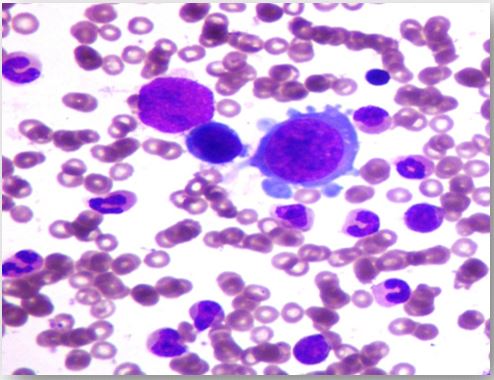

Parvovirus B19 disease post-renal transplant presenting as refractory anemia - case series of 20 patients
Ankur Mittal1, Umapati Hegde1, Mohan Rajapurkar1, Sishir Gang1, Abhijit Konnur1, Hardik Patel1.
1Nephrology, Muljibhai Patel Urological hospital, Nadiad, India
Introduction: Transplant patients are susceptible to a wide range of infections, one of which includes Parvovirus B19 (PVB19). In a post-renal transplant patient, due to failure to mount a neutralising antibody response to the virus, PVB19 causes significant morbidity & also graft dysfunction. It is usually present in the first year of the post transplant period, associated with anemia and non specific signs and symptoms.
Methods: We retrospectively reviewed all transplant recipients from the period 2013 to 2020. 20 recipients were found to be positive for Parvovirus B19. when tested for evaluation of anemia. We looked at the epidemiology, clinical spectrum and outcome of patients with post-transplant PVB19 infection. Parvovirus B19 polymerase chain reaction (PCR) was done for all patients for the diagnosis. Bone marrow examination (BME) was also performed on 8 patients.
Results: The prevalence of Parvovirus infection was 2.16% (20/924). The median time to onset of PVB19 disease was 39 days post-transplantation. Clinical presentations include fever, generalized weakness; dyspnea and myalgia in 50%, 75%, 25% and 40% respectively. Anemia, leucopenia, and thrombocytopenia were present in 100%, 20%, and 10% of patients, respectively.

50% of patients with Parvovirus disease had graft dysfunction evidenced by a 30% elevation in the serum creatinine from baseline. 5 patients developed PVB19 after treatment for acute rejection and 4 patients developed acute rejection after reduction in the immunosuppression for treatment of PVB19. Almost all patients (95%) had a positive PVB19 PCR and the remaining one patient had Typical Giant cell on Bone marrow aspiration.
Hypocellular marrow was seen in 87.5% of patients who underwent BME. Reduction in Immunosuppressant therapy was the most commonly used modality of treatment. IVIG, Packed cell transfusion and Erythropoietin therapy were also used. Two out of 20 patients had their graft lost.
Conclusion: ParvovirusB19 is a rare but clinically significant cause of as refractory anemia during the early post-transplantation. The use of PCR for diagnosis and reduction in immunosuppressants particular antiproliferative agents is the mainstay of treatment.

right-click to download